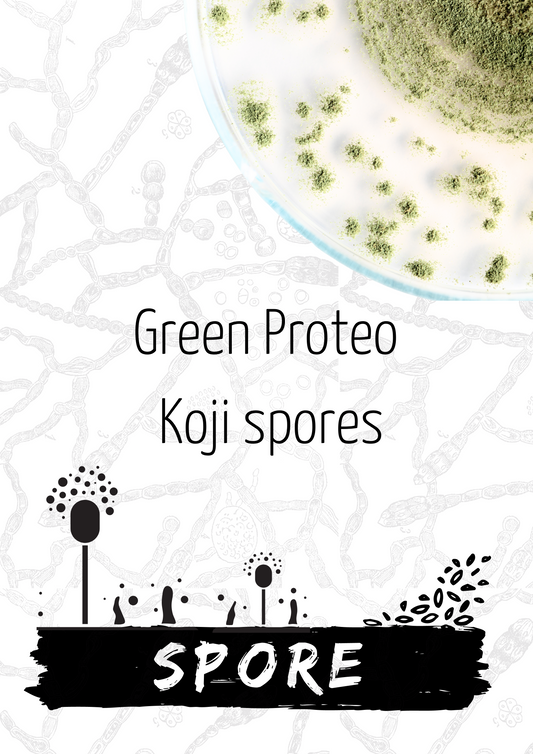
Green Proteo Koji Spores

-
64-18 sake | Junmai quasi dai
Fornitore:risosakePrezzo di listino €26,00 EURPrezzo di listinoPrezzo unitario perPrezzo di vendita €26,00 EUR -
Corniolashu
Fornitore:Riso SakePrezzo di listino €18,00 EURPrezzo di listinoPrezzo unitario perPrezzo di vendita €18,00 EUR -
Degustazione Nihon Cha - tè verde giapponese - 03.08.2025 -
Fornitore:giappone nel cassettoPrezzo di listino €15,00 EURPrezzo di listinoPrezzo unitario perPrezzo di vendita €15,00 EUREsaurito -
Dellarole DRY | Ancient rice variety
Fornitore:risosakePrezzo di listino €26,00 EURPrezzo di listinoPrezzo unitario perPrezzo di vendita €26,00 EUR -
Eusake02 | 1° italian Sakamai
Fornitore:risosakePrezzo di listino €26,00 EURPrezzo di listinoPrezzo unitario perPrezzo di vendita €26,00 EUR -
Facciamo i MOCHI - ISCRIZIONE GRATUITA
Fornitore:FermentazioniPrezzo di listino €0,00 EURPrezzo di listinoPrezzo unitario perPrezzo di vendita €0,00 EUREsaurito -
Green Amilo Koji Spores
Fornitore:risosakePrezzo di listino Da €12,00 EURPrezzo di listinoPrezzo unitario perPrezzo di vendita Da €12,00 EUR -
Green Proteo Koji Spores
Fornitore:risosakePrezzo di listino Da €12,00 EURPrezzo di listinoPrezzo unitario perPrezzo di vendita Da €12,00 EUR -

EsauritoHarmoniæ | Aromatic Italian Sake
Fornitore:risosakePrezzo di listino Da €14,00 EURPrezzo di listinoPrezzo unitario perPrezzo di vendita Da €14,00 EUREsaurito -
Koji Bianco 500g
Fornitore:risosakePrezzo di listino €14,50 EURPrezzo di listinoPrezzo unitario perPrezzo di vendita €14,50 EUR -
Koji integrale 500g
Fornitore:risosakePrezzo di listino €14,50 EURPrezzo di listinoPrezzo unitario perPrezzo di vendita €14,50 EUR -
Koji WILD 500g
Fornitore:risosakePrezzo di listino €15,60 EURPrezzo di listinoPrezzo unitario perPrezzo di vendita €15,60 EUR -
Lamon Miso - 250g
Fornitore:FermentazioniPrezzo di listino €9,50 EURPrezzo di listinoPrezzo unitario perPrezzo di vendita €9,50 EUR -
Marascashu
Fornitore:Riso SakePrezzo di listino €18,00 EURPrezzo di listinoPrezzo unitario perPrezzo di vendita €18,00 EUR -
MARASCHE IN FERMENTO
Fornitore:fermentati del coppePrezzo di listino €5,00 EURPrezzo di listinoPrezzo unitario perPrezzo di vendita €5,00 EUR -
Mövat | Italian Sparkling Sake
Fornitore:risosakePrezzo di listino €18,00 EURPrezzo di listinoPrezzo unitario perPrezzo di vendita €18,00 EUR
-
KOJI
MORE ABOUT KOJIl koji è una preparazione che ha origine da due ingredienti, il riso e il fungo Aspergillus Oryzae. L’unione del fungo sotto forma di polvere, al riso cotto, produce una muffa bianca superficiale sul riso. Questo è il koji, l'anima della produzione del nostro Sake. Il koji, in quanto "alimento fermentato" è ricchissimo di enzimi sviluppati dai miceli del genere Aspergillus come ad esempio proteasi, lipasi, lattasi,
amilasi, glicomilasi e endofitasi. Il koji in cucina apre nuove frontiere e diventerà velocemente un ingrediente fondamentale in ogni cucina professionale. Già utile come ingrediente tal quale è inoltre una fonte di enzimi per "fermentazioni" davvero originali.
“Questi organismi producono enzimi, gli enzimi sviluppano aminoacidi, acido glutammico + acido aspartico = umami, umami = delizioso”. -
SAKE KASU
MORE ON SAKE KASUIl sake-kasu nasce come sottoprodotto della pressatura del sake e si potrebbe definire come l'equivalente della vinaccia nel vino. A Differenza di essa però il kasu ha una consistenza cremosa ed in oriente non è mai visto come uno scarto, ma bensì come ingrediente fondamentale di moltissimi piatti. Il Kasu ha molteplici applicazioni. Viene utilizzato per la marinatura di verdure, pesce e carni, nelle preparazioni denominate Kasuzuke donando delle caratteristiche note di fermentazione mantenendo le note aromatiche dei nostri piatti ma cancellando quelle sgradevoli tipiche ad esempio del pesce e pollame. Altri utilizzi tradizionali giapponesi lo prevedono come ingrediente per la preparazione di gelati e di pane in cassetta, ma è anche un antichissimo segreto in fatto di cosmetica, utilizzato fin dai tempi antichi dalle geishe per la loro pelle perfetta e setosa.